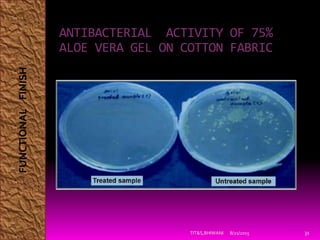
8/21/2015TIT&S,BHIWANI 31
ANTIBACTERIAL ACTIVITY OF 75%
ALOE VERA GEL ON COTTON FABRIC
FUNCTIONALFINISH

The document discusses textile finishing processes. It begins by defining textile finishing as processes used to impart functional or aesthetic properties to fibers, fabrics or clothing through physical and chemical treatments. It then classifies finishes as either functional or aesthetic based on whether they improve performance or modify appearance. Several specific finishing processes are described in detail, including crease resistance, antimicrobial finishing using natural extracts like neem, and flame resistance. The document provides information on how these finishes work and their benefits.


![IMPORTANCE
To improve fabric attractiveness.
To improve serviceability.
To give desirable qualities to fabric.
To improve the feel of the fabric.
To cover faults in the original fabric.
To improve wearing qualities of fabric by making it shrink or
crease resistant.
To set garment shape. E.g. Durable press.[4]
To import special properties to the fabric for special end uses such
as waterproofing, flame-proofing etc.
To strengthen the fabric by coating or laminating.
To produce novelty effects e.g. organdie fabrics by parchment
sing
8/21/2015 3TIT&S,BHIWANI](https://image.slidesharecdn.com/seminarontextilefinishing-151129183451-lva1-app6892/85/Seminar-on-textile-finishing-3-320.jpg)

![Functional Finishes improve
the performance
properties of the fabric ;
like durability, strength etc.
Antimicrobial/Antiseptic
Crease resistant
Durable Press
Flame Resistant
Mothproof
Shrinkage Control
Soil Release
Water Proof/Repellant
Aesthetic Finishes modify the
appearance and /or hand or
drape of the fabrics.[5]
Mercerization
Napping And Sueding
Shearing
Softening
Stiffening
8/21/2015 5TIT&S,BHIWANI](https://image.slidesharecdn.com/seminarontextilefinishing-151129183451-lva1-app6892/85/Seminar-on-textile-finishing-5-320.jpg)













![ Creasing can be controlled by physical deposition of
a suitable polymeric material in amorphous region.[1]
Or the hydroxy groups of adjacent macromolecules
may be reacted with bifunctional agents.
Reacting cotton with acidified formaldehyde.
CRF finishes are resin finishes.
The fabric is saturated with resin and then the resin
is cured at temperatures of about 360°F.
The fabric becomes stiffer, less absorbent and more
resistant to wrinkling.
8/21/2015TIT&S,BHIWANI 19
FUNCTIONALFINISH](https://image.slidesharecdn.com/seminarontextilefinishing-151129183451-lva1-app6892/85/Seminar-on-textile-finishing-19-320.jpg)
![ADVANTAGES:
Improves comfort.
Decreases pilling. [2]
Increases ease of maintenance.
Betters dimensional stability.
Chemical treated cotton fabric dry more easily.
DISADVANTAGES:
Decreased breaking strength( up to 28%).
Decreased tearing strength.( up to 19%)
8/21/2015TIT&S,BHIWANI 20
FUNCTIONALFINISH](https://image.slidesharecdn.com/seminarontextilefinishing-151129183451-lva1-app6892/85/Seminar-on-textile-finishing-20-320.jpg)






![CHITIN
Chitin, is a natural, non-toxic , microbial resistant and
biodegradable polymer.[3]
Chitin is one of the most abundant polysaccharides
found in nature , derived from marine shells and
mollusks.
Chitin is applied on to the fabric by padding the
cotton fabric with a mixture of chitin and citric acid
followed by high temperature curing.
The fixation of chitosan citrate solution onto cotton
fabrics followed by dry- cure process.
8/21/2015TIT&S,BHIWANI 27
FUNCTIONALFINISH](https://image.slidesharecdn.com/seminarontextilefinishing-151129183451-lva1-app6892/85/Seminar-on-textile-finishing-27-320.jpg)
![NEEM
8/21/2015TIT&S,BHIWANI 28
Photographs of (a) untreated and (b) neem seed
extract (5% w/v) treated cotton/PET blend (against
B.Subtilis bacteria)[6]
FUNCTIONALFINISH](https://image.slidesharecdn.com/seminarontextilefinishing-151129183451-lva1-app6892/85/Seminar-on-textile-finishing-28-320.jpg)